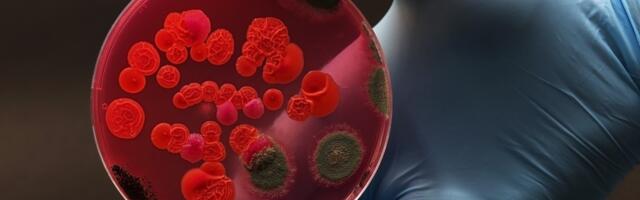
Cheshire-based biotech scores £30m Series A round

322 place 0
Centauri Therapeutics, a biotech company based in Cheshire’s Alderley Park, has secured a £30m Series A funding round to support the completion of clinical studies for its antimicrobial treatments. The drug discovery company, which develops immunotherapy treatments, is working towards the completion of Phase I clinical studies for CTX-187, its lead clinical candiate in the ...
A newsletter a day!
You may get 10 most important news around midday in daily newsletter. Press the button and we will send you the most important news only, no spam attached.
LIKE us on Facebook so you won't miss the most important news of the day!
An East Bay apartment complex has been bought at a price that's well below its prior value. Read more ›
0
A PG&E Corp. unit has bought a San Jose building in a move to bolster the utility's South Bay operations. Read more ›
0
An anonymous reader quotes a report from The Guardian: Bumblebees can use tools to solve a problem, according to experiments that demonstrate their remarkably advanced cognitive abilities. The bees were given an adapted version of an experiment that, 100 years ago, first demonstrated chimpanzees could work out how to retrieve an out-of-reach banana by stacking boxes. Since then, various other primates, elephants and crows have joined an elite cohort of... Read more ›
0 newcommer
The next RedMagic tablet is launching in China as the RedMagic Tablet 5 Pro this month, that much has already been confirmed by the brand. We expect this to be branded Astra 2 internationally, since the original Astra was a rebranded Tablet 3 Pro for global markets, and the number 4 was skipped due to tetraphobia). Today the RedMagic Astra 2 has been certified for sale in China by the... Read more ›
0 fresh
Advertising In The AI Age The ₹30 Lakh trademark fine on Google in the Hindware case may be modest, but… Read more ›
0 fresh
Filtr is a new privacy-focused tool that aims to block ads and trackers across nearly every app on iPhones, iPads, and Macs using Apple’s built-in filtering systems. Read more ›
0 fresh
Senior U.S. officials have held preliminary discussions with major artificial intelligence companies about the federal government possibly acquiring shares in their firms, the publication Notus reported, citing people familiar with the matter. The preliminary discussions have centered on having ... Read more ›
0 fresh
Here's the answer for "Wordle" #1812 on June 5 as well as a few hints, tips, and clues to help you solve it yourself. Read more ›
0 fresh
The NYT Strands hints and answers you need to make the most of your puzzling experience. Read more ›
0 fresh
Alan Ni confirms TNG eWallet is actively exploring agentic payments as the next frontier for Malaysia’s most-used digital wallet. The TNG Digital CEO sees Bank Negara’s progressive stance as a signal that the regulatory ground is shifting in the right direction. On the sidelines of TNG Digital’s Media Briefing 2026, after the cameras had stopped ... Read more ›
0 fresh
Connections is a New York Times word game that's all about finding the "common threads between words." How to solve the puzzle. Read more ›
0 fresh
Meta has launched Creator Assistant, a conversational AI tool built into the Facebook creator dashboard that analyzes your content performance, explains why it worked, and suggests new ideas based on trending content. Read more ›
0 fresh
A WIRED investigation claims Meta quietly embedded facial recognition technology into its smart glasses ecosystem, reviving privacy concerns around biometric surveillance and wearable AI. Read more ›
0 fresh
A new rumor from China today claims the upcoming Xiaomi 18 Pro Max will have a 200MP main camera using a 1/1.28" type "new generation" LOFIC sensor. The phone also allegedly has a 200MP periscope telephoto camera with 3x optical zoom and f/2.4 aperture. This camera uses a 1/1.56" type sensor. The telephoto camera will support macro shooting from approximately 15cm. This is a wildly different setup compared to the... Read more ›
0 fresh
If you've been struggling to sleep and end up feeling fatigued during the day, the data collected by these sleep trackers can help you find a solution. Read more ›
0 fresh
I compared the Samsung M80H mini-LED and Samsung QN80H Neo QLED TVs 2026 TVs side by side ready for the World Cup: it reminded me of the Samsung QN90F's greatness. Read more ›
0 fresh
Perhaps Kayla Sims (@lilsimsie) was destined to play The Sims, Electronic Arts' hit life simulation franchise. Read more ›
0 fresh
Google is expanding Ask Gemini in Drive by letting users add Gmail threads as sources for AI-powered answers, summaries, and cross-referenced workplace insights. Read more ›
0 fresh
Bowers & Wilkins has launched its new 800 Series Diamond D5 speakers with upgraded acoustics, redesigned cabinets, and luxury finishes for audiophiles and studio professionals. Read more ›
0 fresh
Всем доброго времени суток. Здесь будет описана история происхождения архитектуры мета-трансформеров, которая описана вот здесь. Как я в августе 2025 года, скучая на выходных, дал двум ChatGPT-4o свободно общаться между собой, как из этого родился крайне сырой концепт "рефлексивного ядра", и как значительно позднее, в феврале-марте 2026 это косвеннным образом привело к открытию крайне интересной находки, которую я назвал механизмом мета-внимания. Запустить Цикл 02 Read more ›
0 fresh
Inherent, a London-based AI lab that aims to reinvent the scientific method, has emerged from stealth with a $50m (£37.2m) fund raise. Founded by former staff of DeepMind, Microsoft and the White House, Inherent is planning to create what it calls the playbook for AI-native science. It is building an AI system called Faraday, named ... Read more ›
0
MokN, a cybersecurity company specialising in anti-credential theft, has secured a $15m (£11.1m) funding round led by Google Ventures. The London-based company has developed a “Phish-Back” solution designed to outsmart attackers attempting to steal credentials by recovering them before they can be used. Among its methods is a ultra-realistic decoy access points that mimic the ... Read more ›
0
The global photonics market is projected to exceed £1tn by 2030. While the UK’s 3.5% share might appear modest, that is still an £8.6bn sector employing more than 84,000 people across 1,400 companies. The Council for Science and Technology has recently warned however, that the UK is losing its window to lead. Industry experts have ... Read more ›
0
The UK and France have signed a new science and technology deal that will provide funding for partnerships between research teams from the two nations. The agreement, announced by Tech Secretary Liz Kendall ahead of the upcoming G7 talks in Paris, will centre AI and data access to support technological innovation. In particular the agreement ... Read more ›
0
This week’s UK tech funding deals include AI scientific research lab Inherent, biomaterials company Mykor and more. UKTN tracked £102.7m worth of UK tech investment this week (25 May to 29 May), a 20% week-on-week decrease across six funding rounds. Here’s your weekly roundup of UK tech startup funding deals. Inherent – £37.2m Sector: AI ... Read more ›
0
Geordie AI, a London-based security and governance platform for AI agents, has raised a $30m (£22.3m) Series A round led by Balderton. The startup’s platform helps businesses to understand, secure and govern their AI agents, providing a real-time understanding of which agents exist, what they can access, how they behave, and the risks they create ... Read more ›
0
Lune & Wild has raised £2m in a Series A funding round led by Guinness Ventures to scale production, expand its retail footprint and build on its mission to redefine what children eat. Lune & Wild is an organic baby and children’s food brand built on chef-crafted recipes, specialist paediatric nutrition and ingredient sourcing. The ... Read more ›
0
AI-powered insurance platform Sapiens is moving its company’s headquarters to central London, located in Holborn’s Space House. The Israeli tech firm’s agentic platforms help insurers automate the manual workflows surrounding insurance operations, improving execution efficiency and accuracy across policy underwriting, claims management, pricing and risk management, and billing. In addition to being the company’s global ... Read more ›
0
Laverock Therapeutics has been awarded two new grants totalling in excess of £2.2m to support the next generation of its gene-control platform development and expansion into additional non-oncology therapeutics areas. The biotech is developing disease-responsive advanced therapies through its programmable gene control technology. To date, Laverock’s gene-control platform has been demonstrated across therapeutic applications and ... Read more ›
0
As London gears up for another packed month of technology events, the global spotlight is once again turning towards the capital. June has become a marker in the international tech calendar, as London has become one of the key hubs where investors, founders, researchers, policymakers and major technology firms converge at scale. From the second ... Read more ›
0
Most popular sources
|
|
0% |
|
|
0% |
|
|
0% |
|
|
0% |
|
|
0% |
| View sources » | |
LIKE us on Facebook so you won't miss the most important news of the day!
04.06.2026 23:49
Last update: 23:35 EDT.
News rating updated: 06:40.
What is Times42?
Times42 brings you the most popular news from tech news portals in real-time chart.
Read about us in FAQ section.